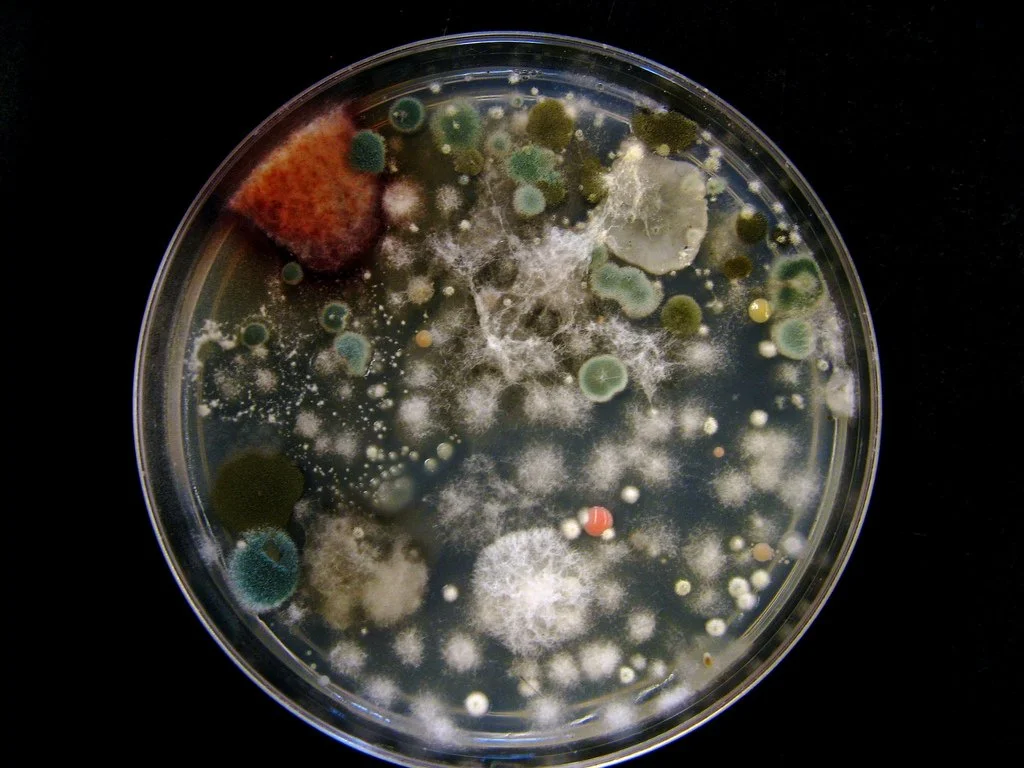

Protein Requirements in Severe ME/CFS Patients
If you have ME/CFS, chances are you’re not eating enough protein. The loss of lean mass in a bed bound patient can be 100-200 grams/week, with the effects most pronounced in the first few weeks.
Candida Overgrowth in ME/CFS and Long-Haul COVID
Gut health and dysbiosis talk are currently all the rage but remember that the gastrointestinal tract begins in the mouth. For years I was plagued with poor dental health. All I needed was a new toothpaste.
Curcumin: A Natural Ally for Fatigue and Inflammation
Curcumin has a long history of use in Ayruvedic medicine for maintaining a healthy inflammatory response. Regular curcumin supplementation relieves brain fog, pain, allodynia, and fatigue.
An Anti-Inflammatory Diet for Fatigue and Pain
What is an anti-inflammatory diet really? Learn the foods to routinely include in your diet to reduce inflammation and the laboratory tests to measure your progress.
What Is a Low Histamine Diet—and Who Should Follow It?
An intolerance to histamine is not considered a typical food allergy, but a pseudo-food allergy. Just as with a typical food allergy, avoidance is key. Read what foods are highest in histamine.
How Viruses Disrupt Mitochondria in ME/CFS and Long COVID
Many common viruses rely on hijacking your cell’s mitochondria in order to replicate and thrive. With exquisite execution, viruses have developed tactics akin to a well-planned siege. Espionage, blitzkrieg, intracellular mutiny…viruses are often victorious, causing long term problems for the host.
Lessons Learned from Tracking Sleep for 9 Months
I wanted to look more closely at my sleep habits to see if I could pinpoint clues that could then be influenced to achieve better sleep. I began to track aspects of my sleep using an app called Sleep Cycle. The results may surprise you…
3 Supplements That Support Ketosis and Boost Fat Burning
Not sure if you’re in nutritional ketosis? You might need an edge to switch over your metabolism. Here are 3 supplemental tricks to help you transition into a ketone burning machine.
Can a Ketogenic Diet Help ME/CFS, Fibromyalgia, and Long COVID?
Have you heard about a ketogenic diet? This is a diet those in the ME/CFS and Fibro community might want to get to know...mitochondrial, immune cell, and brain effects explained
Mold Illness in ME/CFS, Fibromyalgia, and Long-Haul COVID
Unresponsive to traditional treatments? Mold toxin exposure may be holding you back.
Moldy? 4 Ways to Test for Mold Illness & Mycotoxins
With a weakened immune system, the uphill battle to improve ME/CFS can be insurmountable if your everyday environment is against you. One such obstacle may be mold. Find out how to determine if mold is a problem for you…
Arthroben for Joint Support in ME/CFS and Fibromyalgia
Traditional pain relievers for fibromyalgia carry heavy side effects and are often ineffective. A novel medical food called Arthroben may offer a safer solution to peripheral pain in fibromyalgia and arthritic conditions.
Understanding Leptin Resistance in ME/CFS and Fatigue
A new ME/CFS study has put the hormone leptin in the spotlight. With it comes new insights and questions. Find out what it is, how it contributes to symptoms, and how it can be modulated.
A Beginner’s Guide to Chronic Fatigue Syndrome (ME/CFS)
A CFS primer originally written for the readers at GreenMedInfo, I give a thorough synopsis of recent research…
tDCS as a Potential Therapy for Fibromyalgia Symptoms
Transcranial direct current stimulation (TdCS) studies have shown improvements in pain for fibromyalgia patients. The weak electrical currents may also safely improve sleep, cognition, anxiety, and more…
How Medications Can Damage Mitochondria in ME/CFS
An oft forgotten cause of mitochondrial dysfunction is medication usage. Mitochondrial toxicity testing is NOT required by the FDA. What's in your medicine cabinet?
ER Stress: A Hidden Factor in ME/CFS Fatigue
Why do some experience no relief with mitochondrial nutrients? Could it be because mitochondrial damage is NOT the prime driver, but a consequence of something else? Enter the Endoplasmic Reticulum…
5 Antiviral Supplements for ME/CFS and Immunity
Immunovir? Cyclovir? Valcyte got you down? Instead of giving up when the anti-viral drugs stop working, there are several strategies patients can use to intervene in blocking viral penetration and replication.
Best Vitamin B12 Forms for ME/CFS and Fibromyalgia
Recent interest has emerged as to which form of this crucial vitamin to supplement. Here are your 4 choices…
Understanding Dysbiosis in ME/CFS and Fibromyalgia
Did you think there was one kind of dysbiosis? There is more to dysbiosis than a simple imbalance of species. Here I present 4 subtypes of dysbiosis that have direct, indirect, and complex effects on the host—us!